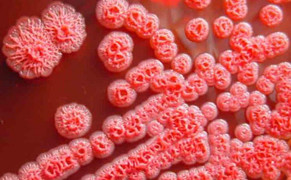
7 biện pháp phòng ngừa 'vi khuẩn ăn thịt người'

7 biện pháp phòng ngừa 'vi khuẩn ăn thịt người'
(VTC News) - Bộ Y tế khuyến cáo 7 biện pháp phòng ngừa bệnh Whitmore hay còn gọi "vi khuẩn ăn thịt người".

(VTC News) - Bộ Y tế khuyến cáo 7 biện pháp phòng ngừa bệnh Whitmore hay còn gọi "vi khuẩn ăn thịt người".
(VTC News) - Whitmore là bệnh nhiễm trùng ở người và động vật do vi khuẩn Burkholderia pseudomallei gây ra.

Một trong hai bệnh nhân mắc Whitmore, điều trị tại Bệnh viện Nhi Trung ương, đã tử vong trong tình trạng suy đa tạng, hoại tử ruột.

Một trong 2 bé trai ở Thanh Hoá phát hiện mắc khuẩn gây bệnh Whitmore sau khi dầm nước mưa.

(VTC News) - Sau khi phẫu thuật cắt lách do áp xe lách và xuất viện về nhà, bệnh nhân có dấu hiệu đau bụng nên nhập viện điều trị, được chẩn đoán bệnh Whitmore.

(VTC News) - Bệnh nhân nhi, 9 tuổi, nhiễm vi khuẩn "ăn thịt người" Whitmore, căn bệnh truyền nhiễm nguy hiểm.